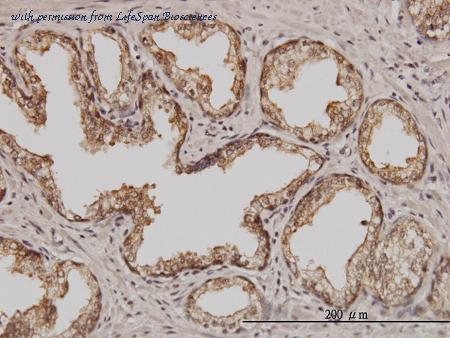

product summary
Loading...
company name :
LifeSpan Biosciences
product type :
antibody
product name :
PSMD5 Antibody (clone 3E2) LS-C133418
catalog :
LS-C133418
clonality :
monoclonal
host :
mouse
conjugate :
nonconjugated
clone name :
3E2
reactivity :
human
application :
western blot, ELISA, immunohistochemistry, immunohistochemistry - paraffin section
more info or order :
citations: 1
| Published Application/Species/Sample/Dilution | Reference |
|---|---|
| Rousseau A, Bertolotti A. An evolutionarily conserved pathway controls proteasome homeostasis. Nature. 2016;536:184-9 pubmed
|
image
image 1 :

PSMD5 monoclonal antibody (M01), clone 3E2 Western blot of PSMD5 expression in A-431.
image 2 :
Immunoperoxidase of monoclonal antibody to PSMD5 on formalin-fixed paraffin-embedded human prostate. [antibody concentration 3 ug/ml]
image 3 :

Detection limit for recombinant GST tagged PSMD5 is approximately 0.1 ng/ml as a capture antibody.
product information
AntibodyID :
137038
AntibodyName :
LS-C133418
TargetSpecies :
Human
Host Species :
Mouse
Product Name :
PSMD5 Antibody (clone 3E2) LS-C133418
Specificity :
Human Proteasome 26S S5
ClonalityDesc :
Monoclonal
CloneName :
3E2
AntibodyModification :
Unconjugated
PresentationDesc :
PBS, pH 7.4
ImmunogenType :
Recombinant protein
ImmunogenDesc :
PSMD5 (AAH14478, 405 aa ~ 505 aa) partial recombinant protein with GST tag. MW of the GST tag alone is 26 KDa.
PurificationDesc :
Purified from ascites by Protein A
RecommendedStorageDesc :
Store at -20°C or lower. Aliquot to avoid freeze-thaw cycles.
IsotypeName :
IgG1,k
Gene :
PSMD5
StandardGeneSymbol :
PSMD5
gene family :
Protease Non Catalytic
Reactivity :
Human
Usage :
ELISA, IHC, IHC-P (3 µg/ml), WB
ShortWebDescription :
PSMD5 antibody LS-C133418 is an unconjugated mouse monoclonal antibody to human PSMD5. Validated for ELISA, IHC and WB. Cited in 1 publication.
UsageText :
Immunohistochemistry: Formalin-fixed paraffin-embedded sections. Sandwich ELISA: Recombinant protein. Western Blot: Cell lysate, Recombinant protein.
Synonyms :
PSMD5, 26S protease subunit S5 basic, 26s proteasome subunit 5b, 26S proteasome subunit S5B, KIAA0072, S5B, Pmsd5
SalesRegion :
Worldwide
more info or order :
company information

LifeSpan Biosciences
2401 Fourth Avenue, Suite 900
Seattle, WA 98121
Seattle, WA 98121
CustomerSupport@lsbio.com
https://www.lsbio.com1-206-464-1554
headquarters: USA
Since 1995, LifeSpan has been the industry leader in molecular pathology, specializing in the localization of proteins in normal and diseased tissues, both human and non-human. We offer more than 74,000 antibodies, custom designed immunohistochemistry (IHC) studies, immediately available human tissue IHC profiles for more than 500 proteins, and histology and pathology services. Our bank of 2 million specimens is available to support our customers' contract research studies and contains frozen and formalin-fixed (FFPE) normal and diseased tissues. Our contract services are comprehensive; they include study design, antibody sourcing and characterization, tissue sourcing and validation, immunolabeling, trouble shooting, and interpretation of the results by a LifeSpan pathologist.
related products
browse more products
- S100A5 Antibody (clone 5E1) LS-C133419 | LS-C133419
- Calgizzarin / S100A11 Antibody (clone 2F4) LS-C133421 | LS-C133421
- SALL2 Antibody (clone 3F7) LS-C133422 | LS-C133422
- MAPK12 / ERK6 / SAPK3 Antibody (clone 1G4) LS-C133423 | LS-C133423
- SARS / Serine-tRNA Ligase Antibody (clone 1H4) LS-C133424 | LS-C133424
questions and comments
